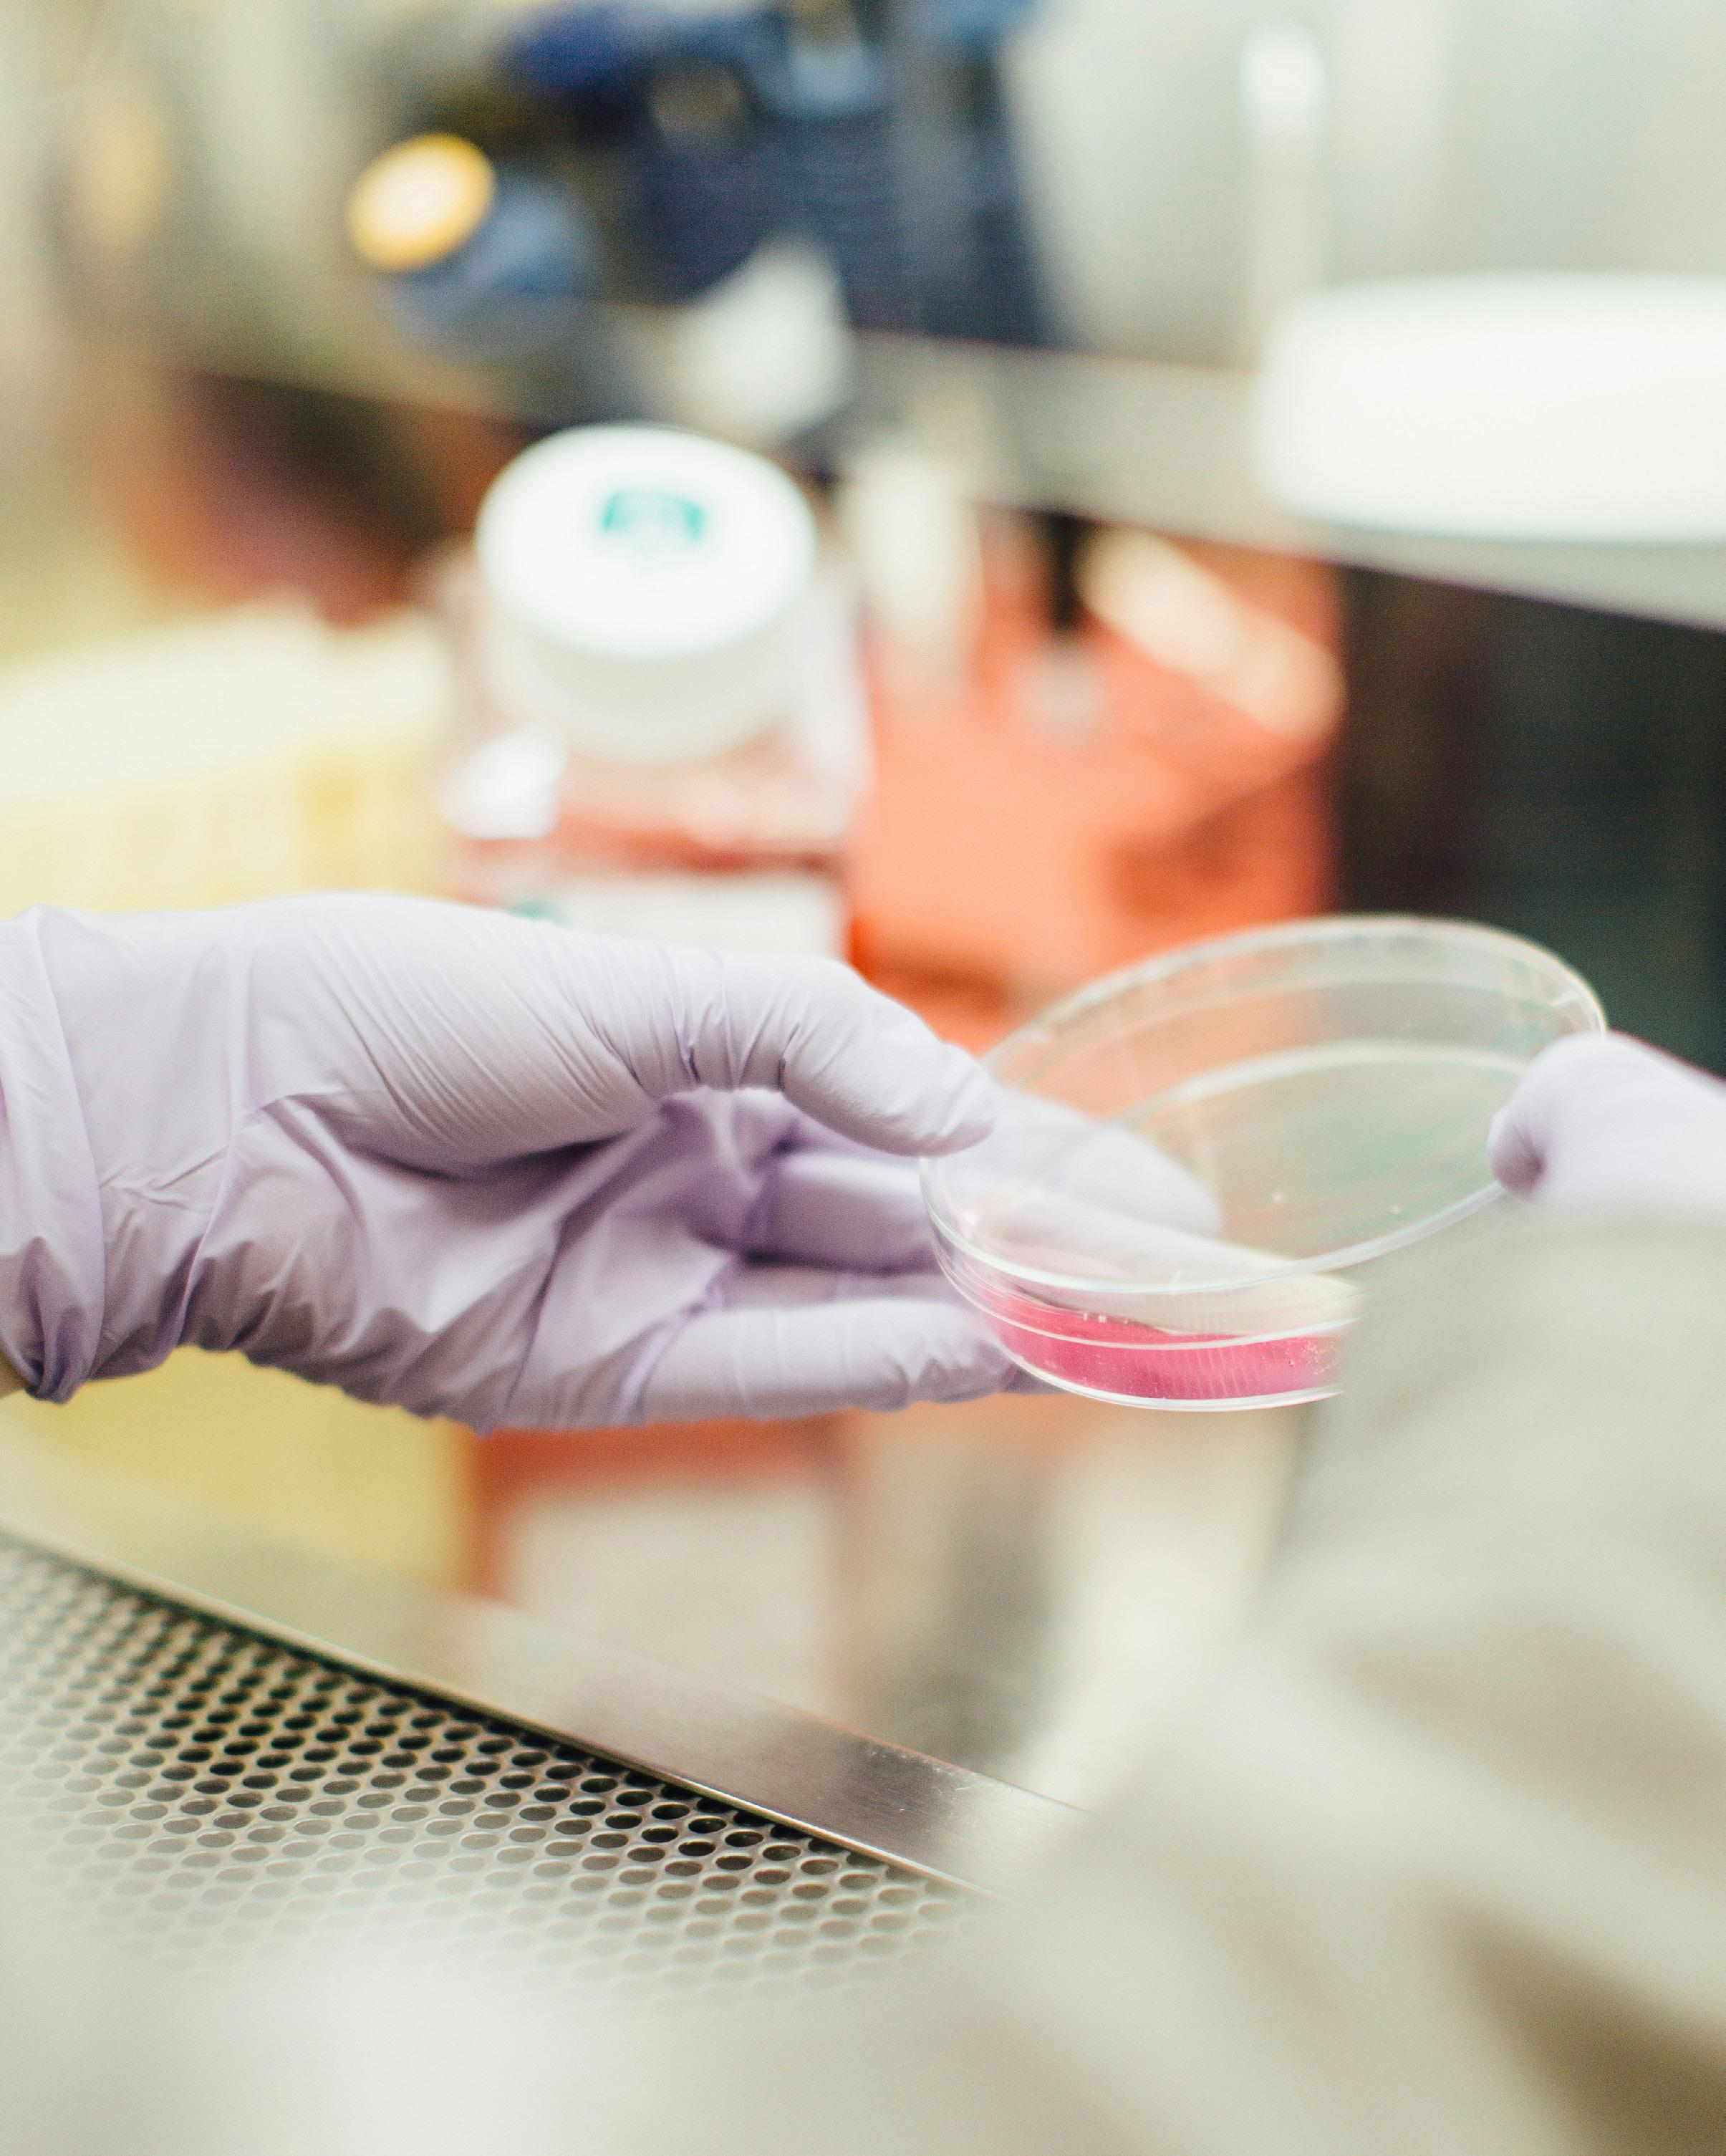

CARTA DE EDICIÓN
p.06
p.17
p.18
p.28
p.36
p.38
p.40
p.44
p.46
p.48
p.50
p.54
p.55
p.56
p.60
p.62
p.66
p.67
p.68
p.73
p.74
p.78
Del caserío al servicio social. Entrevista a Alejandro Santiago Calderón
Anhelos de la nostalgia
Museo Banksy de Nueva York (parte 2)
Muestra fotográfica de estudiantes de fotografía de la UPRRP
Viaje Qlinario presenta: Selena Pizzería
Columna: El Soundtrack de octubre
Ámate antes de vivir
Arte en la historia. Claude Monet: Impresión, Sol Naciente (1872)
Unity Pulse: Reconocimiento de las Identidades No Binarias...
Cinco películas que debes ver en el mes de octubre...
Más allá de una asociación: una esencia
The Book Geek: Puro paisaje
Muerte al PNPPD
Arte protesta (serie 1)
Habla Gamer: Reseña de Alien Romulus
El arte de trabajar con palabras visuales
Horóscopo estudiantíl
El papel del manga en la formación de la identidad cultural japonesa
Arte combativo: Liberen a Palestina
Sexto aniversario
Melanoma gástrico; un Cáncer poco común, pero agresivo
Iniciativas estudiantiles
Fotos provistas por Alejandro Santiago Calderón
Del caserío al servicio social
Entrevista a Alejandro Santiago Calderón
Anabel Matos @amatos.prs
Alejandro Santiago Calderón es Trabajador Social Clínico, Activista de Derechos Humanos y producto del caserío. Es Especialista en Capital Humano y Cultura Organizacional. Además, fue aspirante al Senado por Acumulación en el Precinto 4 del Municipio de San Juan por el Movimiento Victoria Ciudadana.
VA - ¿Qué lo motivó a postularse para el Senado de Puerto Rico bajo el Movimiento Victoria Ciudadana?
Como siempre he mencionado, soy una persona que viene de un residencial público, producto del sistema de educación pública de este país y del Departamento de Vivienda, y también me he beneficiado de la asistencia nutricional que ofrece el Departamento de la Familia. En cierto aspecto, he recibido todas las asistencias públicas y es una forma de poder devolverle al país lo que invirtió en mí, sin lugar a dudas, era precisamente, hacerme disponible en momentos históricos e importantes en los que estamos viviendo, donde se nos va la vida si nos ponemos en manos de la administración acual nuevamente. Soy un activista gay, visiblemente negro y que viene de un espacio empobrecido y esta no es la tradición dentro de la política pública en Puerto Rico. Quizás yo hubiera sido una vez más, la minoría en este espacio. Cuando miras mi perfil dentro
de todas las candidaturas, incluso del partido en el que estuve afiliado (Movimiento Victoria Ciudadana), soy la minoría. Por lo general, los partidos están conformados de personas que tienen ciertos privilegios y mi condición siempre fue que mencionaran que soy un servidor público, un hombre negro, gay y que soy una persona que está dentro de la pobreza y que todos los días lucho contra ella. Por otra parte, el tema de la política siempre me ha gustado y como trabajador social de profesión, me parece importante la inserción de las personas que estamos todos los días apagando fuegos, ofreciendo servicios a las poblaciones vulnerabilizadas y para las personas que desconocen totalmente lo que es el día a día en Puerto Rico desde “chamaquito”, fuera del colegio, pues el país que diseñan no se ajusta de ninguna manera a la realidad de nuestra gente. Estas son algunas de las razones por las que me postulé para el Senado. Originalmente, me postulé para el Precinto 4 del Municipio de San Juan, pero debido a luchas internas y egos que se dan en todos los espacios, no pude ir a ese escaño. Sin embargo, otra persona me reclutó y pude aspirar al Senado por Acumulación, reconociendo que yo iba a ir sustituir (y lo digo con todo el cuidado y responsabilidad del mundo), a nuestra compañera, la actual senadora Ana Irma Rivera Lassén, del cual tengo un perfil muy similar en temas que defendemos,
en temas que nos generan mucha pasión aprender, aunque tenemos diferencias de edad y de trayectoria, la puedo considerar como una mentora.
VA - Como trabajador social clínico, ¿cuáles son sus tres principales propuestas para mejorar la calidad de vida en Puerto Rico?
Mi primera propuesta desde la misión del trabajo social, que es en donde trabajo y hago discusiones, es precisamente, reconocer la realidad de nuestro país empobrecido. Si bien es cierto que las personas que viven en los residenciales públicos experimentan desigualdad. Así que, esa es mi primera propuesta, mejorar la calidad de vida en los residenciales públicos, impulsando el desarrollo económico en estos espacios, dándole oportunidades de empleos, porque una persona que vive en un residencial público, tan pronto comienza a trabajar, se ve en la obligación de pagar renta rápidamente. Entonces, tienes a una persona que está en este espacio en negativo, economicamente hablando, y cuando miras al nivel de una cuenta bancaria está en negativo. Eso es lo que también pasa por ejemplo, en Haití. En este país, la deuda es tan grande que los donativos que entran es para pagar esa cuenta en negativo y lo mismo ocurre con las personas que viven en estos espacios públicos. Están en negativo y cuando comienzan a trabajar, no pueden salir de este ciclo de pobreza en el cual el Estado los somete. Mi propuesta sería tener un crédito para que cuando las personas comiencen a trabajar, por al menos en un periodo de seis meses a un año, no tuviesen que pagar renta y estabilizar sus finanzas y luego de ese tiempo, pagar la renta como cualquier persona y de esta manera pudiera ser más “jugoso” para un residente tener la oportunidad de hacer ahorros personales y afrontar la vida en otros aspectos.
Por otra parte, la segunda propuesta que quería trabajar son los derechos laborales en Puerto Rico que han sido violentados en
todos los tiempos, y en este último cuatrienio, los derechos laborales de las personas trabajadoras han sido sepultados y en ese sentido, iba a presentar legislación. Además de ser trabajador social, me estoy formando como Especialista en Recursos Humanos, me encanta el tema del derecho laboral. Hemos visto es que las personas que trabajan por servicios profesionales, no cuentan con leyes justas y suficientes que los protejan. Una de las cosas que quería legislar es que el pago de contribuciones sobre ingresos fuera escalonado. Es decir, que ese pago, si una persona tiene un contrato de $2,000 dólares al año, no debería pagar el 10% que paga toda aquella persona que trabaje por servicios profesionales, sino, un porciento menor. No es lo mismo un contrato de $2,000 dólares en un año versus tener un contrato de $50,000 dólares o incluso tener un contrato multimillonario que pueda cubrir muchas personas, ¿verdad? Que son los llamados “buitres” en nuestro país y que pagan el mismo 10%. Y eso pues no es justo. ¿Por qué? Porque tú tienes personas que están cobrando muy poco cuando tú les quitas ese 10%, las contribuciones que tienen que pagar, la mayoría de ellos están ganando por debajo del minimo establecido en Puerto Rico. Esa es mi segunda propuesta en términos económicos.
Y la última y no menos importante, en esa misma dirección, es que queríamos consolidar que en Puerto Rico se rescatara el modelo educativo-vocacional en nuestras escuelas; fortalecerlo. Que si bien es cierto que existe, este modelo fue uno que impulsó la economía y el desarrollo de nuestro país en los años 70, 80, hasta el presente, pero que poco a poco ha decaído por diferentes circunstancias. Entre ellas, por ejemplo, si yo le doy Artes Culinarias a Alejandro en una escuela vocacional, que sale con las competencias y la habilidad de insertarse en la clase trabajadora y que quizás no ve la necesidad de seguir estudiándolo porque, seamos honestos, a menos que tú no quieras un cargo exageradamente

elevado en el campo de las artes culinarias, no necesitas seguir estudiando. Con tres años de una escuela vocacional, sales con el conocimiento suficiente para cocinar, servir la mesa e incluso para ser dueño de tu propio negocio en el campo del servicio de alimentos, pero, ¿qué ocurre? El negocio de la educación vocacional no es favorable para todos los institutos y universidades que diariamente dan cursos técnicos. Así que esas son tres partes de las cosas que quería trabajar, entre otras cosas como temas de salud pública, acceso a la vivienda, cuidado de los adultos mayores y derechos humanos.
VA - Desde su labor como activista, ¿de qué forma representa las necesidades de las comunidades LGBTQ+, a las personas que viven en residenciales públicos, las mujeres y otras comunidades que han sido marginadas en la Isla?
Bueno, llevo en el activismo desde el 2013 aproximadamente, me tomó un poquito menos.
Nunca he necesitado, una plataforma política ni ningún partido para llevar la voz, incluso, soy de las pocas personas que llevo el activismo, por decirlo, de manera independiente, pues por mi forma de ser, lo que no me gusta, lo denuncio, aunque seamos “panas” todos que compartimos la misma mesa, si está mal, está mal, y eso me ha traído, de alguna manera, el tener que hacer el activismo desde mis propias capacidades. Nunca he tenido problema en continuar haciéndolo, y siempre mi convicción me lleva a hacerlo. De la forma que sea necesaria. Digo esto porque el que yo no haya alcanzado a ser certificado como candidato oficial, o que no haya aparecido en una papeleta, eso no me va a limitar, y como trabajador social, tengo las herramientas suficientes para continuar haciendo defensa. Así que, como activista y trabajador social, planificamos, continuar la defensa por los derechos de las personas de las Comunidades LGBT+, presentando proyectos de ley, o incluso levantando la voz en los espacios más necesarios. En el tema de los
adultos mayores, una de mis pasiones es, en algún momento, poder tener algún centro de cuidados para los adultos mayores, otra de las áreas donde no he llegado, y que eventualmente, espero que se presente la oportunidad de unirme a las instituciones que sean necesarias para poder continuar trabajando con este tema. Por otra parte, con las poblaciones de los residentes de los residenciales públicos, estoy apoyando en este momento a algunos candidatos, asesorándoles sobre la importancia de incluir políticas reales. En un futuro habrá una oportunidad de poder evaluar la participación, que más allá de uno proponer un proyecto u otro, es que sean las mismas comunidades quienes lo generen. Así que parte del proceso que vamos a estar llevando a cabo es que después de las Elecciones en noviembre, estaremos evaluando aquellas posiciones políticas donde no haya habido algún cambio, porque más allá de que pertenezca al rojo o azul, si la persona no sirvió, pues no sirvió. Yo no soy de los que creen que hay que sacar a las personas porque es parte del bipartidismo. En todas las estructuras políticas hay gente buena y hay gente mala. Lo importante es que si el que se quedó no ha hecho el trabajo,

pues el momento de desplazarlo. Así que, sí la oportunidad de que haya una persona que haya prevalecido, es como uno lo espera. Entonces, buscar la manera de continuar haciendo ese trabajo de comunidad para luchar por los derechos de las poblaciones que mencionas: Mujeres, adultos mayores, personas que viven en residenciales públicos y las Comunidades LGBTQ+. Hay que reconocer que estas son todas interseccionalidades. Puedes encontrarte dentro de un residencial público un adulto mayor que sea LGBT y también pasa con las mujeres. Así que esas son las interseccionalidades que pueden existir en una misma persona, y desde esa realidad, hay que hacer políticas públicas y no solo eso, sino también proyectos que garanticen el desarrollo de estas poblaciones.
En Puerto Rico hay un gran problema. Y que muchas veces, te encuentras con organizaciones que tienen los fondos suficientes para atender las necesidades de las poblaciones vulnerabilizadas. Pasa mucho con las personas sin techo, gastan demasiado capital en promociones menos en techos, porque no están fiscalizadas. Por ejemplo, gastan demasiado capital comprando bolígrafos para promocionar la organización. Entonces te encuentras una persona sin techo, pero con más de diez bultos de diferentes organizaciones que trabajan con el mismo tema. Toda una colección de bolígrafos, casi por edición. En la medida que van asignando fondos, se hace un diseño diferente. Estuve leyendo sobre una investigación que hizo el CPI (Centro de Periodismo Investigativo), que hablaba de las personas sin techo en Ponce, pero allí hay un sistema coordinado para atender a las personas sin techo. Y yo no quiero echarle lodo al trabajo que se hace, es que en Puerto Rico hay un problema de fiscalización y el trabajo, por lo general se cumple con metas muy bajas (pocas personas) y ya con eso hacen los números de la propuesta. Aparte que estratégicamente, a nivel de propuesta y con esto concluyo, ¿Cuál es la meta que estableces para alcanzar tu proyecto
y el cumplimiento? “Pues vamos a impactar a dos personas”. No te ponen que vamos a sacar de las calles a dos personas. No, es que “vamos a impactar” dentro del concepto del impacto en el algoritmo de las organizaciones, es precisamente, darles un bolígrafo, darles un sandwichito y en esa actividad, evidentemente, van a sobrepasar los números. ¿Por qué? Porque en una actividad de una persona sin hogar pueden llegar 15, 20 o 30 personas, ah, pues ya lo lograste. A veces, sí otorgan los fondos y los vales a los que están en las calles, pero no necesariamente se les hace un seguimiento. Por ejemplo: Alejandro estaba en la calle, le dimos una vivienda, aunque en 24 horas Alejandro la haya abandonado, sigue contando como que se la di. ¿Solucionamos realmente el problema?. Y eso pasa con muchos otros temas.
VA - ¿Cuál es su postura sobre la crisis energética en Puerto Rico? ¿Qué soluciones propone para lograr un sistema energético y sustentable?
Bueno, esta crisis energética que hemos vivido en Puerto Rico, ha llegado a ser como la cadena alimentaria. La luz no está y ya tenemos consecuencias en nuestro sistema, en nuestras circunstancias, en las personas que vivimos, trabajamos y buscamos sobrevivir en la Isla. Puerto Rico, siendo una isla, tiene mil formas de generar energía. Por ejemplo, el sol, la hoy convicta y exrepresentante María Milagros Charbonnier, en su nefasto y corrupto desempeño político en el año 2018, me parece, propuso el impuesto al sol. Un impuesto donde la gente iba a pagar por “utilizar el sol”, y hoy vemos cómo muchas compañías no reguladas están vendiendo placas solares que no le garantizan a la gente su funcionamiento y sobre todo, en un país donde hoy estamos tranquilamente hablando y mañana hay una tormenta, las placas pueden salir volando, y no se le garantiza a la gente que su hogar funcione. Entonces, hay que buscar otros modelos que de alguna manera garanticen energía renovable. Por ejemplo, recientemente salió una noticia donde
“Nunca
he necesitado, una plataforma política ni ningún partido para llevar la voz, incluso, soy de las pocas personas que llevo el activismo, por decirlo, de manera independiente, pues por mi forma de ser, lo que no me gusta, lo denuncio, aunque seamos “panas” todos que compartimos la misma mesa, si está mal, está mal, y eso me ha traído, de alguna manera, el tener que hacer el activismo desde mis propias capacidades.”
República Dominicana, un país que siempre lo hemos visto con desprecio y como un destino turístico, este lugar donde muchas vamos de vacaciones y vuelvo a mi país, nos hace ofertas para lanzarnos un cable submarino a Puerto Rico para darnos luz. Ahí es cuando dices, Puerto Rico está tan malo que este país, que en el pasado estaba tan empobrecido, hoy nos toca la puerta para decirnos: Vengo a ayudarlos. Pero, peor aún, Puerto Rico se encuentra rodeado de cuerpos de agua. Esta no es mi área de expertise, pero hay cosas básicas. Yo pensaba que en el pasado, para el tiempo de mis abuelos, existían plantas de generación de energía hidráulica con el movimiento del agua. ¿Cuántos cuerpos de agua tenemos en Puerto Rico? ¿Por qué no volvemos a ese modelo? En situaciones de emergencia, por ejemplo, un Huracán María, donde va a haber demasiada agua, poner a funcionar estas plantas por lo menos puede servir para que nuestros hospitales no colapsen, para que nuestras instituciones donde se brindan servicios de emergencia continúen operando. Puedo entender que en el pasado, no teníamos la misma cantidad de gente y la misma cantidad de enseres eléctricos y ese sistema no sustentaba lo suficiente, quizás, pero por lo menos puede servir de alguna manera para algo en la actualidad, y me parece que lo usan poco. En el pasado funcionó y la gente vivía con el sistema eléctrico que se generaba por medio del agua y otras alternativas. Incluso en países vecinos como Colombia, particularmente en Guatapé, Medellín ellos tienen sistemas hidráulicos para generar luz y le venden luz a otros países como Venezuela, Nicaragua, etc.,y se genera de cuerpos de agua. Puerto Rico tiene muchísimas otras formas de poder generar energía renovable, energía que se sustenta en los mismos recursos que tenemos. Lo que no tenemos es la voluntad de hacerlo. No tenemos ni la voluntad ni la capacidad ni queremos alcanzarlo en un mejor país. Y es fundamental que, cualquier persona que pueda leer esta entrevista, sienta el llamado. Que diga: “Oye, yo me quiero formar como profesional en eso.
¿Cómo yo puedo desde mi formación?” Y esa es una práctica que me ha traído mucho éxito. Cuando ven mi resumé y me dicen, “wow, tú has trabajado en muchas cosas”. Y es que desde bachillerato dije: yo voy a trabajar y estudiar. Cuando no tenía oportunidades de trabajo, me hice disponible de manera voluntaria. Y es el voluntariado lo traduces en conocimiento. Entonces, eso me ha dado mucho éxito y desde que yo comencé mi bachillerato, el tema de mi profesión siempre fue personas que son parte de la Comunidades LGBT+ y temas relacionados a comunidades desiguales. Aunque mi bachillerato, por ejemplo, no fue no en Trabajo social, cuando yo salía al mercado a buscar oportunidades, me decían, wow, tú sabes tanto sobre estos temas. Y es porque yo me tracé esa meta: Yo quiero ser de los mejores en esos temas. Así que, el consejo aquí es que si usted va a ser ingeniero, inserte el tema de su especialidad y busque como lograr destacarse entre sus colegas sin necesidade de hacerles daño. A lo mejor usted termina siendo el mejor o el que salva el patrimonio, o el ingeniero del estado, o lo que sea, la profesión que sea. Pero es que necesitamos un llamado de que nuestras juventudes se inserten. Siempre hemos crecido con la idea de que las juventudes son la voz del futuro y eso hay que romperlo. Somos el presente. A nivel cognitivo, yo tengo 34 años, uno se pregunta cuándo uno deja de ser joven o cuándo es que me toca hablar. Tienes que generar los espacios. Por ejemplo, una entrevista como esta, jamás pensé dar la entrevista para la Universidad Ana G. Méndez, dada las realidades que experimenté. MI contexto no era poder hacer cosas que yo he logrado. De lo cual, también me siento orgulloso porque soy profesor certificado en dicha institución. Pero cuando tú miras esto desde la realidad que la que estoy en el trabajo social como joven de residencial público y que viene de muchos espacios de violencia, esto no es para olvidar esto es para celebrarlo. También se piensa que las demás personas pueden. Y, verdad, volviendo al tema de la energía, así como cualquier persona puede alcanzar un salario,



también puede invertir en capacidades, en poder recobrar el país. Me parece que tenemos la alternativa. En Puerto Rico, por ejemplo, llegó un momento donde las algas marinas ocupan nuestros espacios. ¿Podemos inventarnos algo para que las algas sean procesadas y generen energía? No sé. ¿Tiene una posibilidad? A lo mejor sí. ¿Podemos, en la medida que vamos modificando agua para el consumo de nuestra
“República Dominicana, un país que siempre lo hemos visto con desprecio y como un destino turístico, este lugar donde muchas vamos de vacaciones y vuelvo a mi país, nos hace ofertas para lanzarnos un cable submarino a Puerto Rico para darnos luz. Ahí es cuando dices, Puerto Rico está tan malo que este país, que en el pasado estaba tan empobrecido, hoy nos toca la puerta para decirnos: Vengo a ayudarlos.”
gente, generar energía? Posiblemente. ¿En la medida que los carros vayan transitando por nuestras calles? ¿Podemos hacer carreteras que generen energía? Por lo menos para el alumbrado de los mismos postes de luz de las calles. Posiblemente. Tenemos grupos musicales como Coldplay, una banda muy buena que conocí hace un tiempo. Y dije: los voy a apoyar ¿Sabes qué me motivó a apoyarlos? Que ellos, en sus conciertos, generan la energía mientras el público se divierte. Es decir, ellos tienen estaciones de bicicletas estacionarias donde la gente se puede sentar a pedalear. Tienen como un tipo de transporte, no necesariamente, pero es como una pista en el suelo que la gente puede brincar mientras escucha la música y eso va generando energía. Si un grupo de música lo puede hacer para sentarse en un concierto, ¿cuánto más podemos hacerlo nosotros? A lo mejor es costoso, pero hay que mirar, ¿la inversión vale la pena en este momento?. El centro comercial más grande del Caribe, que lo tenemos en Puerto Rico, ¿podemos hacer que nuestros estacionamientos, cuando la gente vaya a subir al multipiso, en la medida que va pasando eso, me generen energía? ¿Podemos hacer que el primer piso o el segundo piso de este local, cuando la gente esté caminando, me genere energía y sea un costo mínimo para mí como empresa? Hay mil formas. Hay mil formas de poder hacerlo. ¿Podemos generar energía en nuestras universidades, en este pasillo donde es más concurrido mientras la gente va a comprar comida, va caminando?. Hay mil formas de buscarlo, y Puerto Rico tiene la capacidad de hacerlo. Lo que hay que hacer es invertir en nuestra juventud.
VA - Ya en modo de cierre, para los electores que aún no se han decidido si van a participar del proceso electoral o a quién le darán su voto, ¿qué mensaje final les daría para convencerlos a que salgan a votar este próximo 5 de noviembre?
Bueno, a todas las personas que quieran salir a votar, es importante que puedan estudiar quiénes
son esos candidatos que van a llegar y que van a estar en esas papeletas. Es fundamental y necesario que las personas puedan buscar alternativas reales. Mi camino en la política no termina en este momento de la descalificación. Mi camino en la política comienza y todas las personas hacemos política. Desde el que se levanta a ir a la universidad hasta la mujer trabajadora que deja a sus niños cuidados y se va a trabajar y luego sale a las cinco de la tarde a buscar a sus niños. Eso es hacer política. Así que, es momento en que todas las personas votemos y la oportunidad que tenemos para cambiar el país es este próximo 5 de noviembre. Si las personas no se han decidido por “x” o por “y”, usted mínimo inscribase. Lo peor que uno puede hacer es no inscribirse y después el 5 de noviembre, teniendo dos meses y medio, ya sea tarde y quiera salir a votar y no pueda hacerlo. Es fundamental que las personas nos podamos inscribir y tengamos un tiempo suficiente para ver cuáles son las personas que se postulan en nuestras regiones y en nuestros municipios. ¿Qué la persona debe buscar? La papeleta nacional, la papeleta a la alcaldía y las papeletas por precintos y estudiar qué ofrece cada persona, cuáles son mis intereses y sobre todo, dejar de votar por traición. Votar porque mi abuela me dijo, que mi mamá recibió el empleo de tal. Si tu mamá es buena, si tu familiar es bueno y tiene la competencia, tu mamá no va a perder el trabajo. Ahora bien, si tu mamá llegó por “pala”, simplemente, quizas pierda las oportunidades, eso tambien es parte del proceso. Hay que comenzar a fomentar que la juventud no solo se inserte en el mismo espacio político, sino que también se inserte en el desarrollo de nuestro país. Y yo estoy convencido de que las personas tienen la capacidad de hacerlo. Ya sea porque Bad Bunny les invite o sea el cantante, el artista que lo haga, tenga la convicción de tener ese espacio para poder estudiar sobre ese problema. Son temas densos. Utilice la inteligencia artificial si usted quiere utilizarla. Hágale preguntas, me gustan estos temas, quiero tener un trabajo
mejor, mejor educación, mejor vivienda, hable con ChatGPT. ¿Qué candidato usted me sugiere bajo estos criterios para mí? Y yo le aseguro que estos ChatGPT lo va a ayudar. Si lo que tenemos es inteligencia artificial, para lo que usted que no conoce, utilice uno de estos mecanismos. El punto es que el 5 de noviembre si alguien no vota, la decisión queda en algunas personas. Aunque yo reconozco que para algunas personas votar es una manera de protestar. En este momento, en nuestro país, hay que salir a votar. Porque en la medida que alguien no vota, ganan los mismos de siempre y gana siempre quien más capital tiene en su campaña. La política es un proceso de mercadeo. No siempre el mejor, o el de mayor convicción es el que está promocionándose. Muchas veces, el que mas promoción tiene, es el candidato más malo. Y el mejor candidato no tiene esa influencia política para poder promocionarse. Dicho esto, mi invitación es que todas las personas salgan a votar. Elijan a la persona que entiendan más competente. En este caso, yo no voy a estar en la papeleta. No obstante, les invito, cuando ustedes estudien su papeleta, y salgan a votar, y si van a votar por La Alianza, les recomiendo estudiar sus candidaturas. Aprendan lo que es un voto mixto y lo que es un voto por candidatura. Es importante, incluso pueden imprimir sus papeletas en el modelo que ya está disponible. Y usted las imprime, hace su, lo que llamamos en las universidades, la droguita. O sea, va a los nombres. Y usted se vaya a votar con su Sharpie, hace la marca dentro del cuadro y la marca al lado de los nombres si uested quiere que la persona llegue y su voto se cuente. En el caso de La Alianza, no puede votar debajo de los símbolos de los partidos porque no estaríamos cumpliendo con La Alianza y puede que dañe su papeleta. Es importante que vote al lado del nombre que usted quiera elegir, por lo menos en la papeleta. Y de esta manera yo estoy seguro que podemos hacer el trabajo. Yo prefiero sentir la frustración de que no hayamos ganado si fuese el caso que sentir la frustración de que pude haber participado y no lo hice. Son
dos cosas totalmente distintas. Es como con nuestras familiares. Tenía tiempo de compartir con un abuelito y una abuelita y no lo hice y ahora que no los tengo, los extraño. Son cosas muy similares. Así que, salgamos a votar y a rescatar a nuestro país.
Si deseas conocer más del trabajo de Santiago Calderón, puedes seguirlo a través de @ alejandrosantiagots tanto en Instagram, TikTok, Facebook y Twitter. El está en todas las plataformas. Incluso, pueden buscar su nombre en Google como “Alejandro Santiago Puerto Rico” y ahí encontrarán toda su trayectoria y todas las cosas que ha estado haciendo en los últimos años. Su página web es alejandrosantiago2024.com. Ahí también pueden encontrar parte de lo que es su campaña política y que va a seguir siendo una plataforma para difundir su proyecto, futuras actividades y todas las cosas que hacen.
Es importante saber que el voto es libre, es secreto, es tu derecho y nadie te lo puede quitar.
Si deseas ver un cambio positivo en Puerto Rico, te exhorto a que le des la oportunidad a otras personas cuyas intenciones son el bien colectivo para todxs lxs habitantes de Puerto Rico.
Anhelos de la nostalgia
Wanda I. Miranda Adorno
Hoy quiero tener una cama de pilares de aquellas adornadas con un velo que nos guardaba de intrusos diminutos que pinchaban la carne, como el ingrato amor que nos pincha el alma.
Hoy quiero una mecedora de pajilla, como aquella en la que mi madre me mecía y me cantaba.
Quiero también el sofá y la butaca donde la familia se juntaba; y al calor del amor y la ternura los minutos desfilaban, como si nuestra sola existencia llenara el universo y era la riqueza que a todos nos bastaba.
Quisiera ver nuevamente el fogón y la leña de la casa del abuelo y aquel plato de arroz con el olor a humo, donde el tizne dejaba las marcas de unas manos delineando el amor con que nos era prodigado.
Quiero escuchar el canto del coquí y desde la baranda del balcón de madera ver la luna y las estrellas.
Quiero sentir el crujir de aquellas viejas tablas de la pequeña sala que al son de mis carreras infantiles eran estremecidas cual se estremece el alma cuando besas... y no piensas en nada.
Quiero el aroma de las rosas, de las chinas y toronjas... y el sabor y la tibieza de la leche recién sacada, y aquel café humeante que me servía la tía en un cacharro o en una vieja taza.
Quisiera disfrutar las cosas que se han ido aunque la nostálgica vivencia dure sólo un momento. Un momento bastará para vivir ese recuerdo que llevaremos en el alma hacia el destino eterno.
Museo Banksy de Nueva York (parte 2)
José Ernesto
Estudiantes de fotografía de la UPRRP Muestra fotográfica
La hora feliz - Kalianne N. Burgos Santiago
Gota de Afflición - Genesis Ruiz Morales
El laberinto de la hormiga - Quisqueya Díaz Pimentel / Criptas - Quisqueya Díaz Pimentel
Sin título - Alexander J. Santiago Virella
Miss Earth - Christoher Rivera
Otis - Ana Lucía Morrow Ortega
Auto retrato - Laura Gutierrez Marin
Viaje Qlinario presenta: Selena Pizzería
José O. Dávila Figueroa
Amante de la buena gastronomía, ya no tienes que preocuparte por escoger un buen lugar para comer. Me he tomado la tarea de buscar los mejores lugares de comida, asegurándome de que, además, puedas economizar. Así que lleva tu paladar a viajar y síguenos en este Viaje Qlinario.
Llegamos hasta el Paseo de Diego, en Río Piedras. Esta zona, al igual que la Calle Loíza y la Calle Cerra, se encuentra en desarrollo como un destino artístico y gastronómico. No solo nos impresiona con su arte, sino que también podemos encontrar joyas culinarias. En este caso, escogimos a Selena Pizzería. Esta pizzería nos ofrece el icónico slice de pizza newyorkina, dándole su propio toque a las recetas y sabores a los que estamos acostumbrados.
En su menú podemos encontrar seis pizzas distintas: Flavia, Luisa, Teresa, Selena, Fanny, Elisa y Pili. Aquí podemos degustar desde la típica pizza de queso, pasando por la meat
lovers, hasta la vegetariana. Cabe destacar que los nombres de las pizzas son de familiares o mujeres célebres. Mis favoritas son la Selena, que tiene salsa roja, mozzarella, bacon, pepperoni con sirope de maple, y la Elisa, que tiene salsa blanca, mozzarella, bacon, cebolla, alioli de ajo y parmesano. Por otro lado, si buscas algo vegetariano, tienes la Pili con pesto vegano a base de pistacho, calabacín y tomates cherry, o la Fanny con salsa roja, calabacín, pimientos, cebolla morada y sirope de maple picante.
En cuanto a precios, fluctúan desde los $3 dólares hasta los $5, pero recordemos que son slices estilo newyorkino, así que son pedazos más grandes de lo que usualmente vemos en las pizzerías. Sin embargo, los martes, al presentar tu tarjeta de estudiante, puedes disfrutar de un slice y un refresco por $5 dólares. Ya saben, disfruten del arte plasmado en las paredes, edificios de Río Piedras y de las ricas pizzas de Selena Pizzería.
¡No te pierdas la segunda temporada! Todos los viernes a las 10 am.
https://linktr.ee/houndmag
Columna: El Soundtrack
Isis Mercado Rivera
Bienvenidos de vuelta a El Soundtrack, el espacio donde exploramos el amor por la música y cada playlist acompaña el mood perfecto. Este mes es particularmente especial: Octubre no solo celebra mi cumpleaños, sino también mi festividad favorita, Halloween. Amo Halloween porque nos da la oportunidad de expresarnos, de ser creativos con nuestros disfraces y de mostrar nuestra personalidad más auténtica. Y si combino mi amor por este mes con la música, solo puedo pensar en una década: los 80’s, la mejor era musical (en mi opinión, claro).
Los 80’s están llenos de algunos de mis artistas, películas y canciones favoritas. Crecí escuchando música de esta época, lo que me llevó a descubrir mi amor por el género alternativo. Este playlist está lleno de clásicos icónicos de los 80 que, para mí, capturan a la perfección las vibras de Halloween. Son imprescindibles en cualquier fiesta de disfraces. Si aún no has explorado la música de los 80, este es el momento perfecto.
Este playlist combina mood de misterio y una energía de party, perfecto para el espíritu de Halloween. Cada canción te transporta a una fiesta ochentera, te sentirás como si estuvieras protagonizando una película clásica de terror. Ponte tu mejor disfraz, suelta tu imaginación, y déjate llevar por estas canciones que llenarán tu Halloween de sorpresas. Conviértete en quien quieras ser y, al mismo tiempo, siéntete más tú mismo que nunca.
¡Espero que disfrutes este playlist y que tengas el Halloween más duro de tu vida!
El playlist:
https://open.spotify.com/playlist/1tWbiHzLSE2W5Mj4BRcesj?si=bafd17b338dd4e9e
Playlist:
1. I Was Made For Lovin’ You - KISS
2. Sunglasses At Night - Corey Hart
3. Somebody’s Watching Me - Rockwell
4. You Spin Me Round - Dead Or Alive
5. Tainted Love - Soft Cell
6. Maniac - Michael Sembello
7. Bad - Michael Jackson
8. Maneater - Daryl Hall & John Oates
9. Goo Goo Muck - The Cramps
10. Abracadabra - Steve Miller Band
11. Super Freak - Rick James
12. Girls on Film - Duran Duran
13. Another One Bites The Dust - Queen
Ámate antes de vivir
Natalia Sánchez Dávila
¿Quieres apreciar la vida? ¿Quieres disfrutar de los pequeños detalles? ¿Quieres dar amor y recibir? Entonces, tienes que amarte y conocerte antes de todo eso. Porque créeme, estar con una persona cuando tú te sientes horrible contigo mismx, vivir la vida con pensamientos estresantes en tu mente en cada momento, pensando constantemente en personas o cosas que no valen la pena, no conocerte a ti mismx, no amarte a ti mismx: es tener una vida miserable. No lo estás disfrutando, no la estas viviendo. ¿Cómo piensas disfrutar de la vida si cuando te levantas no quieres hacer nada? ¿Cómo piensas enamorarte cuando ni te amas a ti mismx? ¿Cómo piensas que las personas se enamoren de ti cuando te ves al espejo y solo ves basura? ¿Cómo piensas querer
que las personas te vean inteligente y bonitx cuando tú apenas te ves así? ¿Qué esperas con todo eso? Nada. No puedes esperar nada porque no estás haciendo nada por ti mismx.
El amor propio. Si no te amas, no vives. El tema sobre el amor propio se ha vuelto popular entre las redes sociales, algo así como una «tendencia». Pero al parecer casi nadie lo conoce a profundidad. Conozco a personas que dicen amarse, pero al enfrentarse en una situación entre una chica o un chico que no le da lo que realmente se merece, esas personas eligen a esa persona ante a ellos mismos. Y es ahí en donde me pregunto, ¿dónde diablos está tu dignidad? ¿Dónde diablos está tu amor a ti mismx? Porque al final, quien estará para ti,
serás tú. Una frase que me salió hace poco de Bárbara de Regil en un podcast (un elefante en la habitación) me hizo recordar nuevamente que el amor propio es importante para encontrarte. Para empezar a vivir. Ella dijo: «lo único que me salvo fue el amor propio. Suena cliché, pero el amor propio realmente te salva. Es lo único que te salva, tú eres la única persona quien te puede salvar 100%». Y es por eso por lo que el amor propio es fundamental antes de empezar a amar a otra persona. Si eres una persona negativa, una persona que no tiene límites, objetivos o metas, una persona que diariamente se siente miserable, mal consigo mismx, ¿crees que una persona se fijaría en ti? Dime, ¿qué aportas siendo así? No hay nada llamativo en ti, no hay nada atractivo en ti. No estarás en boca de nadie porque no eres interesante. Tu compañía no es requerida porque ni tú mismx te soportas. Pero si eres una persona que realmente sabe lo que quiere, lo que piensa, que tienes sus propias creencias y opiniones, tienes metas y te amas a ti mismx, serás una persona interesante, una persona atractiva. Tu compañía, tu sola compañía iluminará la vida de alguien porque eres inspiración, irradias amor y positividad. Y para empezar a amarte a ti mismx, tienes que mirarte al espejo como la persona que deseas ser. Empezar a actuar como deseas ser. La frase típica que usamos ante nuestra primera entrevista o lo que sea: «la primera impresión siempre importa». Es correcta, pero yo digo que en vez de «la primera impresión» debería ser, «toda ocasión importa» porque tú deberías sentirte bonitx en todo momento porque así es tu personalidad. Y si aplicamos esa frase a nuestra vida cotidiana, nunca nos llevaremos sorpresas. Porque tal vez hoy encuentres al amor de tu vida, veas a tu enemigx o encuentres a tu ex. Pero también sé que algunas personas no les importa cómo se ven y son sorprendentemente lindxs. ¿Por qué? Porque tienen confianza en sí mismxs. Tienen seguridad y no les importa una mierda las opiniones de las demás personas. Y eso está bien. Porque eso es amor propio. La confianza y la seguridad es parte del amor

propio. Así que, siéntete lindx a tu manera, ámate y nunca te sobre bajes por alguien que no aporta nada especial en tu vida. Y si pasa algo así, solo tienes que decir: «soy demasiado lindx para gastar mi hermosa energía en esta mierda» y salir de ese entorno muy poco para ti.
La dependencia emocional. La dependencia emocional es cuando te apegas a algo emocionalmente, o sea cuando tus emociones dependen de otra persona. Así que, repetiré: ámate antes de amar a otra persona. Porque si empiezas a conocer a alguien siendo una persona vaga y patética, una persona que no sabe hacer las cosas por sí solx, una persona que depende de las opiniones de las demás personas, una persona que no se ama así mismx; estarás obsesionadx de esa persona que estás conociendo porque no tienes nada en que ocupar tu mente. Solo en esa persona, en sus opiniones, su alrededor. Serás una persona dependiente de esa persona. Cuando amas a alguien y estas con esa persona, eso no significa que tus emociones ni tus decisiones dependan de esa persona. Cuando compartes tu vida con esa persona no significa que tienes que dejar la tuya por completo y depender de la suya. Conozco personas que tienen miedo de hacer las cosas sin su pareja. Es como, ¿dónde estabas tú cuando estabas solx? Cierto, ni siquiera conocías el amor propio y mucho menos te conocías a ti mismx cuando estabas solterx. Y después te enamoras y das tu pequeña vida únicamente a esa persona cuando ni siquiera te conoces a ti mismx lo suficiente. Like, wthat the fuck? Para tener una relación sana, porque realmente existen, primero deberías conocerte. Y después conocer a quien sea. ¿Cómo yo quería que alguien llegara a mi vida cuando ni siquiera me amaba a mí misma? Cuando yo misma me sentía miserable con mi propia vida. ¿Qué le podía ofrecer a esa persona? Exactamente: nada. O sea, ni siquiera me podía ofrecer algo para mí misma, imagínate para esa otra persona. Pero te quedas ahí, aguantando porque tú piensas que esa persona es la única persona, que no puedes
hacer nada por ti mismx sin esa persona, y eso es solo dependencia emocional. Te pregunto, ¿así quieres vivir tu vida? ¿Así quieres que sea tu vida? ¿Esa persona realmente te hace bien? ¿Te aporta inspiración, amor o positividad? Son preguntas que debemos hacernos porque valen oros. Pueden salvarte de una vida miserable. En serio pueden hacerlo. ¿Y para qué morir por alguien a quien no le importas una mierda? Mira, cuando te empieces a amar, a priorizar tu paz, a ser selectivx; la vida te cambiará. El universo, Dios o cuál sea tus creencias, estarán ahí para ti. No sientas miedo de quedarte solx por un tiempo. «A veces solo debemos alejarnos de todo para encontrarnos». Y después te darás cuenta de que la mejor compañía que puedes tener es a ti mismx siendo feliz por dentro como por fuera. Sintiéndote en paz lejos de los dramas innecesarios, lejos de la negatividad. Estarás bien, en serio. Solo trabaja para conseguirlo. Lo lograrás. Como dijo nuevamente Bárbara en el episodio: «decidirlo. En el momento en el que lo decides, lo haces. O sea, vas para adelante.» Porque si realmente quieres cambiar tu vida, lo harás. Solo necesitas organizarte, enfocarte y tomar la decisión. Y por supuesto, mantenerte firme con esa decisión.
Tu entorno. Cuando hablé sobre ser selectivos, quise decir tener límites. Imagina que vives en una burbuja abierta para todos con quien hables. Tu vida está abierta para todas esas personas. Ellos ven cuando lloras, ellos ven cuando estás feliz, ellos ven si algo paso en tu familia o amistades. Ellos ven tu vida, pero no la conocen a profundidad. Ellos juzgan y hablan a tus espaldas sin saber tu historia, o sea tu vida completa. ¿Por qué? Porque tu vida es pública para todos quienes te ven, pero no te conocen. No eres selectivx, no tienes límites al elegir quien puede o no entrar a tu vida. Ahora imagina que vives en una burbuja que fue hecha para protegerte de todo lo malo, la negatividad, las personas que tienen otras intenciones contigo. Pero ellos no pueden entrar porque tu burbuja tiene una llave que tú solo posees. Es porque
eres selectivx. Tienes límites al hablar con una persona. La burbuja abierta es cuando dejas, pasas o dices tu número, tus cosas personales a personas que solo ves por un momento. Personas que después te darás cuenta de que no tiene sentido que ellos estén en tu vida. Estas literalmente regalando y gastando tu sagrada energía a esas personas. Por ejemplo, compartes un secreto vergonzoso o personal tuyo a algún conocido desconocido pensando que esa persona se ve confiable, pero tú no lo conoces lo suficiente para describirlo bien. Pero después escuchas tu propio secreto entre los pasillos de la escuela. Es una metáfora tonta y que ha salido en múltiples películas, pero puede pasar. So, seamos como dijo Liz (Thewizardliz): «impredecibles, misteriosxs.» Mantengamos nuestra burbuja pequeña y cerrada con personas que realmente valen la pena confiar. Como en nuestra burbuja protectora. No confíes en todos, no le des tu amabilidad a quienes realmente no lo merecen. Sé selectivx, pon límites. Porque es tu vida y nadie tiene el derecho de entrometerse. Nadie tiene el derecho de hacerte sentir pequeñx, vulnerable. Quien lo puede hacer eres tú. Solo tu. Debemos tener en cuenta que no todos somos el agrado de todos, aunque el universo lo manifieste para ti. Incluso la familia puede ser nuestro enemigo. Pero no te estreses por sobre pensar que es tu familia y no puedes alejarte. Si es necesario y realmente puedes, hazlo. No te quedes en donde te tratan mal. Júntate con personas que te busquen, que te sumen y no con personas que buscan de ti a último minuto. Al final, es tu elección como vivir tu vida: la de nadie más. Así que, elige bien. Elige bien a quien le das tu sagrada energía, tu bonita y única personalidad.
Ámate, valórate. Mira, en verdad, cuando empiezas a valorarte te darás cuenta de que mereces todo lo que bueno que la vida puede ofrecerte. Querrás viajar, querrás cuidarte más, querrás todo. Porque es ahí en donde te darás cuenta de que estás siendo la persona que deseas ser. Estás poniéndote al nivel que
mereces estar. O sea, te darás cuenta de que estás empezando a pensar como esa persona que deseas ser. Y lo vas a hacer. Vas a lograr todo lo bueno que pienses porque lo mereces. Así que, deja de quejarte. En vez de quejarte, empieza a moverte. A crear esa vida que tanto deseas y mereces. Hazlo. Y si aún tienes miedo, hazlo con miedo. Es normal sentir miedo porque estás cruzando una línea que tú pensabas que no podías cruzar. Ama tu vida, ama los pequeños detalles que realmente importan. Enfócate en ti, en lo que te suma, en lo que te nutre. Deja de mortificarte, deja de quejarte y busca solución. Ama, ríe, organízate y sé feliz. ¿Por qué no mereces ser feliz? Why not? ¿Por qué no mereces ser valoradx? Why? Si los demás pueden y lo hacen, ¿por qué tú no? Si la persona que estuvo más bajo pudo, ¿por qué tú no? Cada uno sufre a su manera, cada uno vive a su manera, cada uno cumple sus sueños a su manera, ¿por qué tú no puedes hacer tus cosas a tu manera? Hazlo. Deja de mirar en los procesos de los demás y empieza hacer el tuyo. Simplemente hazlo.

instagram.com/blogpn
Arte en la historia. Claude Monet: Impresión, Sol Naciente (1872)
Chaire Galiany
El experimento con la iluminación era la técnica que rodeaba el siglo XIX. Esta técnica se denominó Impresionismo, originada en Francia en la segunda mitad de este siglo. No obstante, la belleza del perceptor es una cambiante, por lo que artistas comenzaron a explorar diversos formatos y empleos de colores para sus obras. El comienzo de un artista se transformaría en este periodo, mientras que las pinceladas rápidas y espontaneas comenzarían a destacar el lienzo de Monet.
Un pintor impresionista francés que revolucionó la visión del arte en el Impresionismo. Claude Monet nació en la ville lumière el 14 de noviembre de 1840. Al igual que otros artistas reconocidos, la familia de Monet se encontraba en una situación económica delicada por lo que se trasladaron al norte de Francia. Claude lograba obtener dinero por medio de la creación de caricaturas las cuales se transformaron en su primera pequeña exposición a la edad
de 15 años en una tienda local cada domingo. Este pequeño artista inundaba su mente con sueños pintorescos, aficionado por la pintura, el arte y los barcos del puerto. En su vida, la influencia del amor por el arte de su tía, MarieJeanne Lecadre, tuvo un gran impacto en sus comienzos como artista. Los colores oscuros eran empleados en los lienzos de este pintor, influenciado por el paisajista Eugène Boudin, el cual le ayudó a descubrir por completo su propósito como pintor, creando a la edad de 17 años su primera obra Vista de los alrededores de Rouelles (1858). Los colores vivos comenzaron a inundar la mente del artista al ser reclutado en el ejército francés y alistado en la caballería africana. Luego de su rescate por medio de su tía y regreso a Francia, Monet comenzó a estudiar en la academia de Charles Gleyre, ampliando su mundo artístico y conociendo artistas como Pierre-Auguste Renoir, Frédéric Bazille y Alfred Sisley. Los colores vivos, pinceladas ligeras y naturaleza despejada comenzaron a tomar sentido en las pinturas del





artista. Luego de circunstancias como el exilio de Paris a Londres y problemas económicos, Monet comenzó a trabajar en Argenteuil, enamorándose de la naturaleza y arquitectura. Su alma artística lo llevo a transformar un bote de remo en un estudio flotante, siendo asociado como el “Rafael del agua”. Visitando Normandía, una región al norte de Francia, logró conectar con su alma de artista, llevado por la curiosidad en la humanidad y la naturaleza, creando la obra Impresión, sol naciente. Claude logró captar el puerto industrial Le Havre, visualizando un sol ardiente de tono naranja amarillento que contrasta con el empleo de tonos fríos verdosos y azulados los cuales logran incorporarse en un paisaje sereno. No obstante, su obra fue criticada por los expertos de arte conservador en ese entonces, debido a sus formas imprecisas, pinceladas poco definidas y falta de ejecución.
A pesar de todas las circunstancias atravesadas por el artista, Claude Monet continuó su ejecución como artista, creando obras como “La pasarela japonesa” (1899) y “Mujer con una sombrilla” (1875). Su influencia como artista logró convertirlo en fundador de ese gran movimiento que transformó el arte, inspirando a grandes artistas como Vincent van Gogh. El alma de un artista siempre permanece en sus obras, por medio de sus colores vividos y pinceladas ligeras, las cuales formaron el barco que se movía por las olas de ese puerto. En ese barco, yacía un artista que no conocía su potencial ni futuro, plasmando la visión de aquel sol naciente en la ciudad de las luces.
Referencia:
Cartwright, M. (2022, abril 04). Claude Monet [Claude Monet]. (A. Cardozo, Traductor). World History Encyclopedia. Recuperado de https://www.worldhistory.org/trans/es/1-20644/claude-monet/
Unity Pulse: Reconocimiento de las Identidades No Binarias: Un Paso hacia la Inclusión
Milo
Z. Díaz Berio
En los últimos años, ha habido un aumento en la visibilidad y el reconocimiento de las identidades no binarias en las políticas y programas de diversas empresas y organizaciones. El término “no binario” se refiere a personas que no se identifican exclusivamente como hombre o mujer. Aunque puede parecer un concepto nuevo, las identidades de género no binarias han existido a lo largo de la historia y en diversas culturas.
El concepto de género binario, que se enfoca solo en dos categorías (hombre/ mujer), fue un constructo impuesto en muchas sociedades no occidentales durante la colonización. Sin embargo, existen numerosos ejemplos históricos de reconocimiento de identidades no binarias. Por ejemplo, en el antiguo Egipto se
reconocían tres géneros: hombre, mujer y un tercer género conocido como Sekhet (sht). En las culturas indígenas de América del Norte, el término “two-spirit” se utiliza para describir a personas con roles de género mixtos, que reflejan tanto la expresión de género como la orientación sexual.
A pesar de su presencia histórica, las personas no binarias han sido marginadas por sistemas legales y sociales que tienden a vincular el género con el sexo biológico, excluyendo así a aquellos que no encajan en las categorías binarias tradicionales. Esta exclusión puede llevar a dificultades significativas para acceder a servicios de salud, reconocimiento legal y otros servicios sociales. Por ejemplo, muchos documentos oficiales, como pasaportes y licencias de conducir, requieren la selección de
un marcador de género binario, lo que no refleja adecuadamente la identidad de las personas no binarias y genera sentimientos de alienación y falta de reconocimiento.
En respuesta a estas preocupaciones, algunas jurisdicciones han comenzado a introducir un marcador de género “X” en los documentos oficiales, lo que permite una mayor inclusión y reconocimiento de las identidades no binarias. Este cambio no solo legitima estas identidades a los ojos de la ley, sino que también ayuda a reducir la discriminación y el acoso, además de mejorar el acceso a la atención médica y otros servicios esenciales.
Aunque el reconocimiento legal es un paso crucial, no es suficiente por sí solo. Es necesario un cambio cultural que desafíe las normas tradicionales del binario de género. Esto implica la revisión de políticas en áreas como la educación, la atención médica y el empleo para asegurar la inclusión de las personas no binarias. Por ejemplo, las escuelas pueden adoptar un lenguaje inclusivo y proporcionar instalaciones neutrales en cuanto al género, mientras que los empleadores pueden implementar políticas explícitas contra la discriminación.
Para avanzar hacia una sociedad verdaderamente inclusiva, es crucial desafiar las suposiciones y estereotipos sobre el género. La educación sobre la diversidad de identidades de género debe formar parte integral del currículo escolar, ayudando a los estudiantes a comprender y respetar la complejidad del género desde una edad temprana. Además, la representación de personajes no binarios en los medios puede desempeñar un papel clave en la normalización de estas identidades, proporcionando visibilidad y validación a las experiencias de las personas no binarias.
El reconocimiento de las identidades no binarias es fundamental para construir
una sociedad más inclusiva y equitativa. Al redefinir los constructos legales y sociales, podemos asegurar que todas las personas tengan la libertad de expresar su verdadera identidad sin temor a la discriminación o exclusión. La diversidad de género no solo debe ser aceptada, sino celebrada como parte integral de la riqueza de la experiencia
Cinco películas que debes ver en el mes de octubre...
Chaire Galiany
El aire comienza a cambiar, moviendo las hojas de los árboles verdosos del verano. El color aceitunado es remplazado por uno cobrizo, una brisa fresca y calabazas iluminadas. El mes de octubre es el comienzo de ese cambio de verano, remplazando gafas de sol por sombreros de brujas y velas. Estas son algunas de las películas que, sin duda alguna, forman parte de esas vibras misteriosas y oscuras.


5. Practical Magic (1998) - El amor está condenado completamente en la vida de esta familia. Conocerás a tu verdadero amor y vivirás ese mundo de fantasía, pero al escuchar el sonido del grillo, sabrás que todo habrá terminado. Sally Owens (Sandra Bullock) crea un hechizo de amor para no enamorarse de su alma gemela y perderlo al igual que toda su familia. El tiempo vuela, Sally logra enamorarse, pero pierde a su esposo al escuchar un grillo, su hermana Gillian (Nicole Kidman) vive su vida al máximo entre amores, bebidas y cigarros, no obstante, la muerte repentina de su pareja transforma la vida de estas dos hermanas en una pesadilla. Un periodo de hechizos, conjuros, un policía misteriosamente parecido al hechizo de Sally y el fantasma de un novio, cambiarán este destino. Una vida atormentada por el fantasma de Jimmy que tratará de asesinar a Gillian aún en el más allá.
4. Corpse Bride (2005) - Un matrimonio arreglado y dos corazones forzados a unirse por un bienestar familiar. La vida de Victor (Johnny Depp) rodea completamente en cumplir los mandatos de su familia. Sin embargo, su vida es arrebatada al más allá al contraer matrimonio con un cadáver accidentalmente mientras practicaba sus votos en el bosque. Un alma en tragedia que vaga por el mundo de los muertos, deseando ser amada y no abandonada. Una tragedia que arrebató la vida de Emily (Helena Bonham) y destrozó su alma en pedazos. Acompaña a Victor en el mundo del más allá, en donde los muertos cantan, los vivos envenenan y el amor es balanceado en una copa.

3. ParaNorman (2012) - Un legado familiar rodea la vida de Norman en una tarde repentina. El fantasma de su tío le advierte de la tragedia que condena el pueblo de Blithe Hollow, un conjuro que hará la tierra temblar y sacará de sus tumbas a los siete cadáveres que fueron protagonistas de un juicio siglos pasados. Un niño que es excluido de la sociedad por mantener un don que le permite ver a los muertos, despreciado por sus conocidos, ignorado por su familia, teniendo una vida en el que solo las almas atrapadas en este mundo son sus verdaderos amigos. El alma de una niña en tragedia que poseía el mismo don, pero fue arrebatada por las siete almas que condenó al fallecer busca venganza, mientras
que Norman tratará de encontrar su lugar de entierro y calmar su ira.
2. The Conjuring: The Devil Made Me Do It (2021) - ¿Qué pasaría si encontraras un tótem debajo de tu casa luego de experimentar sucesos paranormales? La presencia de algo maligno rodeaba la casa de los Glatzel mientras se apoderaba de los cuerpos como recipientes vacíos y arrebataba la vida de las personas a su alrededor. Ed (Patrick Wilson) y Lorraine Warren (Vera Farmiga) deberán enfrentar otro caso que helará las sangres de todos. Un conjuro que conectó la vida de Ed Warren y relaciona casos pasados con la monja que atormenta sus alrededores. Un pastor que guarda objetos que absorben lo maligno mientras que las vidas son arrebatadas y arrojadas en un lago. Una trama en el que el bien y el mal lucharán nuevamente, arrastrando las almas de aquellos que intervengan en su proceso.
1. Beetlejuice Beetlejuice (2024)Beetlejuice (Michael Keaton) vuelve a la
forzando a Lydia a nombrar al innombrable. Beetlejuice….Beetlejuice volverá a la vida de su amada, huyendo de su exesposa y ayudando a Lydia para recuperar a su hija. Viaja en el mundo de Beetlejuice y descubre el verdadero pasado de este gran espíritu que atormenta por diversión la vida de los que desean invocarlo, pero nunca menciones su nombre tres veces.
Todas las imagenes fueron tomadas del internet.
Más allá de una asociación: una esencia
Angelys N. Santiago López
La Asociación de Estudiantes de Comunicaciones, también conocida por sus siglas “AECO”, es una organización estudiantil vigente en la Universidad Ana G. Méndez, Recinto de Cupey, Puerto Rico. Está constituida por un grupo de estudiantes que forman parte de una directiva diversa, para que así de esta forma se logre una organización y el éxito de la asociación.
AECO lleva más de 19 años brindándole un enriquecimiento educativo a cada uno de los estudiantes que deciden unirse a la misión de esta. Cómo todo proyecto a causa de inesperadas situaciones ha tenido sus pausas, pero siempre vuelve a resurgir la esencia de AECO. Encargándose de reunir a estudiantes apasionados por las Comunicaciones, para ofrecerles la participación de actividades extracurriculares, haciendo que estos puedan
obtener un desarrollo profesional en las distintas áreas de su interés.
Cuenta con tres subdivisiones que hacen parte de esta asociación: Revista: Vibras Artísticas, Podcast: Detrás De La Oreja y las actividades de AECO en general: talleres, participación en producciones, actividades para confraternizar, entre otras.
La misión de AECO es “Ofrecer a los estudiantes del Departamento de Comunicaciones un conjunto de actividades extracurriculares que aporten a su experiencia estudiantil y, a su vez, formen individuos que modelen y proyecten la imagen de un comunicador de excelencia.”
A continuación, podrás conocer la directiva que acompañará a los estudiantes apasionados por las comunicaciones este año académico: 20242025.
Angelys N. Santiago López Presidenta
José O. Dávila Figueroa Vicepresidente
Yaivana Rodríguez Agosto Tesorera
Natalia Sánchez Dávila Secretaria
Alsid Alberto Carrión Pereira Relacionista Público
Jean Carlos Ferrer Almodovar Creador de Contenido
Anto Gamunev Profesor Mentor
Nosleemosenlapróximaedición…
https://linktr.ee/aecouagm
The Book Geek: Puro Paisaje, de Lourdes Vázquez
Eddie Ortíz de TheBookGeek
De Lourdes Vázquez, Puro paisaje es el resultado de la revisión de La mujer, el pan y el pordiosero, tomo de dieciséis relatos de su autoría que fuera publicado en México.
La precisión es el arte y nombre del juego en los relatos que conforman Puro paisaje. La suma de pequeñas insistencias, silencios, deslices del lenguaje, repujan una serie de tramas donde el vértigo del narrar coincide con la espesura del poema. Como en el mejor de los momentos de Lispector, en Puro paisaje Vázquez logra una escritura que atrae al espectro y la urgencia de su caricia en la lectura.
Con Puro paisaje, Lourdes Vázquez se reafirma como uno de los pilares fundamentales para una literatura femenina puertorriqueña.
Les invito a descubrir esta belleza de libro.
Disponible en TheBookGeek ($15.95)
www.instagram.com/thebookgeeek
www.facebook.com/thebookgeekpr
Muerte al PNPPD
Isis Mercado Rivera
Arte protesta (serie 1)
Kei
Habla Gamer:
Reseña de Alien Romulus
Carlos Rodríguez Sotomayor
La franquicia vuelve a sus orígenes junto a unos efectos prácticos innovadores.
Alien Romulus es una carta de amor a las primeras entregas de la franquicia. La película sigue la historia de un grupo de jóvenes que busca escapar de su hogar, pero se encuentran con una amenaza aún peor, dispuesta a acabar con la vida de cada uno de los miembros de la tripulación. Esta franquicia es muy querida por los fanáticos, y el propio director tuvo que pedirle consejos a su creador para no manchar su legado. ¿La respuesta de Ridley Scott? ‘NO LA CAGUES’. Esto le sirvió de motivación
para crear una de las mejores películas de ciencia ficción de la década, sumando el uso de efectos prácticos adicionales para hacerla lo más real posible, imitando el estilo de las primeras entregas. El director Fede supo cómo plasmar en pantalla una combinación de terror, suspenso y hasta claustrofobia en sus escenas. La ambientación, la fotografía y la música se mantuvieron en un tono del nivel del drama haciendo que enriqueciera para bien la experiencia para el espectador.
Efectos prácticos
y visuales
A muchos espectadores, incluyéndome, nos llamó mucho la atención el uso y mezcla de efectos prácticos y visuales que tuvo Alien: Romulus. Tanto es así que su enfoque promocional incluyó brindarnos detalles de su ejecución detrás de las escenas. Esto es una muestra de respeto hacia las técnicas que definieron las primeras entregas de la franquicia, manteniendo su atmósfera icónica mientras se adapta a la tecnología moderna. Los efectos prácticos, como el detallado uso de prótesis y maquillaje para los ‘Xenomorfos’’ y ’Facehuggers’ junto con los animatronics que dan vida a las criaturas de manera tangible, generan una sensación de realismo que impacta tanto al elenco como al espectador. Sin embargo, esta producción también recurre y utiliza los efectos visuales para potenciar la narrativa sin restar autenticidad a los efectos prácticos, utilizando CGI de manera mesurada para mejorar las criaturas o crear escenarios imposibles.
Drama
Hemos vivido una década repleta de secuelas, remakes y spin-offs que, la mayoría de las veces, se realizan con el objetivo de sacar provecho económico del público general. Estas producciones suelen tener el simple propósito de explotar una franquicia. Sin embargo, en este caso, la historia es diferente. A diferencia de sus dos antecesoras, Alien Romulus no es una película sobre el origen de los Xenomorfos.
Esta se sitúa unos años después de la primera entrega y antes de Aliens. En otras palabras, esta película sería como una Alien 1.5. La historia está ambientada en el año 2142 y sigue a un grupo de jóvenes que deciden huir de la colonia minera Jackson’s Star en busca de una nueva vida en un planeta más esperanzador. Durante su viaje, se encuentran con una estación espacial abandonada, donde descubren que no están solos. La estación es el hogar de una terrorífica especie extraterrestre conocida como los Xenomorfos.
Elenco joven
A diferencia de otras entregas de la franquicia de Alíen, el director Fede Álvarez eligió un elenco joven para Alien: Romulus con la intención de aportar una nueva energía y perspectiva a la franquicia. Al trabajar con actores jóvenes, Álvarez busca conectar con una audiencia más amplia y contemporánea, además de ofrecer una visión fresca y renovada de la saga. La estrella protagonista es Cailee Spaeny, este año
ha tenido un gran paso por Hollywood por sus películas recientes como: Civil War y Priscilla. La otra joven que hizo un grandioso trabajo actoral fue Isabela Merced en donde su miedo y el estrés del personaje quedó plasmado en pantalla de una forma genuina. En lo personal me encanta la decisión, ya que permite explorar dinámicas y relaciones diferentes entre los personajes, lo que puede añadir profundidad y novedad a la historia atrayendo un público nuevo.
Ficha técnica
Director: Fede Álvarez
Guionista: Fede Álvarez, Rodo Sayaguez
Género: Ciencia Ficción, Terror
Duración: 119 minutos
Música: Benjamin Wallfisch
Fotografía: Galo Oliveras
Montaje: Matthew Hannam
Productora: Scott Free Productions
Distribuidora: 20th Century Studios
Presupuesto: $80,000,000
El arte de trabajar con palabras visuales
Anto
Gamunev
El arte de representar palabras visuales en el diseño gráfico es una disciplina que fusiona la tipografía, la ilustración y el simbolismo visual para transmitir mensajes de manera efectiva y atractiva. Las palabras visuales no solo se leen, sino que también se “ven”, lo que permite que su significado sea amplificado a través de su forma, color, textura y disposición en el espacio.
Tipografía como arte. Uno de los elementos clave en la representación visual de palabras es la tipografía. Cada tipo de letra tiene su propia personalidad y puede evocar diferentes emociones y percepciones. Por ejemplo, una fuente sans-serif moderna y limpia puede transmitir profesionalismo y simplicidad, mientras que una fuente manuscrita puede dar una sensación de cercanía o calidez. Los diseñadores gráficos utilizan estos matices tipográficos para reforzar el tono y el contenido del mensaje.
Composición y jerarquía. La disposición de las palabras en un diseño gráfico también es crucial. Los elementos como el tamaño, el espacio entre letras, la alineación y la ubicación en la página crean una jerarquía visual que guía la lectura del espectador. Un título grande y en bold atraerá la atención primero, mientras que un texto pequeño y sutil proporcionará información adicional de manera secundaria.
Simbolismo y metaforización visual. Además de la tipografía, los diseñadores gráficos suelen utilizar imágenes
o símbolos para complementar y enriquecer el significado de las palabras. Estas imágenes pueden ser literales o abstractas, dependiendo del mensaje. Por ejemplo, una palabra como “crecimiento” podría representarse visualmente con el brote de una planta, lo que añade una capa simbólica al significado.
Color y emoción. El color juega un papel fundamental en la representación de las palabras visuales. Cada color evoca una emoción diferente: el rojo puede sugerir pasión o urgencia, mientras que el azul puede transmitir calma y confianza. Los diseñadores utilizan paletas de colores cuidadosamente seleccionadas para realzar el mensaje emocional detrás de las palabras.
Movimiento y dinamismo. Con la llegada del diseño gráfico digital, las palabras visuales ya no están limitadas al espacio estático. Las animaciones, los efectos de desplazamiento y otras formas de movimiento pueden aportar dinamismo a las palabras, haciendo que su significado sea aún más impactante.
El diseño gráfico convierte las palabras en una experiencia visual rica y multidimensional, donde cada decisión estética—desde la tipografía hasta el color—sirve para comunicar un mensaje más allá de lo textual.
Aquí te dejo algunos ejemplos trabajados por mis estudiantes universitarios de la UAGM Cupey y UPRRP. Algunxs de ellxs es su primera experiencia con el diseño.
Horóscopo estudiantíl
Carlos Rodriguez Sotomayor
Aries
La verdad sobre uno mismo siempre es la más difícil de aceptar, reconoce tus propias debilidades y fallas.
Números de la suerte - 8, 0, 19.
Tauro
Permítete una reflexión cuidadosa sobre tus acciones deliberadas, el primer paso para corregir un error es la paciencia.
Números de la suerte - 34, 11, 23.
Géminis
Atrévete a tomar el mando, los grandes líderes inspiran grandeza en los demás.
Números de la suerte - 5, 17, 29.
Cancer
No subestimes los riesgos debido a un exceso de confianza, esto puede llevarte a cometer errores graves. Números de la suerte - 12, 8, 9.
Leo
Mira más allá de lo físico, La verdadera esencia de una persona se encuentra en su corazón y alma.
Números de la suerte - 4, 22, 13.
Virgo
La fuerza de carácter puede vencer la fuerza en números, demuestra tu verdadero valor en este mes. Números de la suerte - 1, 5, 17.
Libra
Amárrate este mes del amor y la confianza, Amar es confiar. Confiar es creer.
Números de la suerte - 9, 21, 6.
Escorpio
Dedícate a crear tu propio sendero, Si no hay un camino frente a ti, créalo.
Números de la suerte - 34, 6, 11.
Sagitario
La creencia popular no siempre es la correcta, ten tu propio juicio y análisis sobre las situaciones que te rodean.
Números de la suerte - 4, 0, 16.
Capricornio
No te aferres a las personas o las relaciones, aprender a soltar, acepta su ida.
Números de la suerte - 22, 17, 3.
Acuario
El deseo de querer lo imposible puede llevarte por mal camino, distorsiona tu percepción de la realidad y te aleja de lo que realmente importa.
Números de la suerte - 6, 13, 9.
Piscis
Todo acto que realices, hasta el más mínimo tiene una consecuencia.
Números de la suerte - 2, 15, 22.
El papel del manga en la formación de la identidad cultural japonesa.
Bryan Coss
El manga ha sido fundamental en la construcción de la identidad cultural japonesa, trascendiendo su papel de entretenimiento para convertirse en un reflejo de los valores, tradiciones y dinámicas sociales del país. Sus orígenes se encuentran en el arte tradicional japonés, como los ukiyo-e del periodo Edo, que influyeron en su estilo visual y narrativo. Sin embargo, fue en el siglo XX, con figuras como Osamu Tezuka, cuando el manga adquirió su forma moderna, introduciendo personajes y narrativas más complejas que abordaban los cambios políticos, sociales y culturales de Japón.
Después de la Segunda Guerra Mundial, el manga se convirtió en un medio para que la sociedad japonesa procesara las secuelas del conflicto y participara en la reconstrucción social. Las historias de la época solían tratar temas como la justicia, la unidad y el bien común, resonando profundamente con una población que buscaba recuperarse. El manga no solo ofrecía entretenimiento, sino que también exploraba dilemas morales y ayudaba a definir la identidad colectiva de Japón en una nueva era.
Uno de los elementos clave del manga es su capacidad para reflejar la sociedad japonesa. A través de géneros como el “seinen” y el “shōnen”, aborda temas sociales como las relaciones de género, la política, el medio ambiente y la discriminación. Además, transmite valores culturales como la disciplina, el sacrificio y la importancia de las relaciones interpersonales. Esto permite que los lectores se identifiquen con los personajes y sus desafíos.
El manga también ha sido crucial para la proyección internacional de Japón. Obras como Naruto, Dragon Ball y One Piece han llevado aspectos de la cultura japonesa a una audiencia global, consolidando la imagen del país como un centro de creatividad e innovación. A nivel local, este éxito internacional ha fortalecido el orgullo nacional y ha generado debates sobre la interacción entre influencias extranjeras y tradiciones locales.
En resumen, el manga es mucho más que entretenimiento; es una expresión cultural que ha moldeado tanto la identidad nacional japonesa como su imagen en el mundo. Desde sus raíces históricas hasta su impacto actual, sigue siendo un medio para explorar valores y tensiones sociales, mientras refuerza la presencia global de Japón. Su capacidad para conectar con audiencias dentro y fuera del país asegura su continua relevancia, consolidándolo como una de las formas de arte más influyentes.
Arte combativo: Liberen a Palestina
Artístas Variadxs
Arthur Hoornaert
Natalia Lisinicchia
Llinda Catarina
Llinda Catarina
@daphnedoesdesigns
@flyers_for_falastin
on her home.
Reem, age 3, was killed by an Israeli airstrike
Her grandfather Khaled said she was the “soul of my soul.” Clara Leon Daphne D.
Sexto aniversario
Edgar Migenis Rosario
En el susurro del viento te encuentro, padre querido, en cada aliento, como un faro que nunca se apaga, tu luz me guía, tu amor me embriaga.
Las risas compartidas, los abrazos, los momentos grabados en mis lazos, tu voz resonando en mi corazón, un eco eterno, una canción.
Te veo en el alba, en el ocaso, en cada estrella que brilla en el paso, te siento en el canto de los pájaros, en la brisa suave que acaricia mis brazos.
Aunque la distancia nos separe, tu esencia vive, nunca se pare, en cada lágrima que brota en mi ser, te llevo conmigo, hasta el amanecer.
Hoy celebro tu vida, tu legado, los valores que sembraste a mi lado, en cada paso, en cada decisión, tu amor es mi fuerza, mi gran razón.
Descansa, padre del alma, tu recuerdo en mi siempre se calma, y aunque la tristeza a veces me abrace, tu amor es un abrazo que nunca se deshace.
Melanoma gástrico; un Cáncer poco común, pero agresivo
Diana L. Guzmán Martínez (Bióloga y estudiante de enfermería)
Revisado por:
David H. Solís López, MD FACS, Cirujano Hepatobiliar
¿Qué es el melanoma?
El melanoma es un tipo de cáncer que se desarrolla a partir de los melanocitos, las células responsables de producir melanina, el pigmento que da color a la piel. Aunque el melanoma se presenta con mayor frecuencia en la piel, también puede desarrollarse en otras partes del cuerpo que contienen melanocitos, como los ojos (melanoma ocular) y, en casos muy raros, en las membranas mucosas del tracto gastrointestinal, incluyendo el estómago.
Melanoma gástrico
El melanoma primario en el estómago es extremadamente raro. Más comúnmente, los melanomas encontrados en el tracto gastrointestinal son metastásicos, lo que significa que se originaron en otra parte del cuerpo (como la piel) y se diseminaron al estómago.
Síntomas del Melanoma en el Estómago
Los síntomas del melanoma gástrico
pueden ser inespecíficos y se pueden confundir con otras condiciones gastrointestinales. Estos síntomas incluyen:
Dolor Abdominal: Dolor persistente o intermitente en la región abdominal.
Náuseas y Vómitos: Sensación de malestar y vómitos recurrentes.
Pérdida de Peso Inexplicada: Pérdida de peso significativa sin cambios en la dieta o ejercicio.
Sangrado Gastrointestinal: Presencia de sangre en las heces, que pueden ser de color rojo brillante o negras y alquitranadas (melena).
Anemia: Debida a la pérdida crónica de sangre, puede llevar a fatiga, debilidad y palidez.
Diagnóstico del Melanoma Gástrico
El diagnóstico del melanoma gástrico implica varios pasos y técnicas como;
Pruebas Endoscópicas:
●Endoscopia Superior: Inserción de un tubo
flexible con una cámara para visualizar el estómago.
Biopsia Endoscópica:
●Toma de muestras de tejido durante la endoscopia para examen histológico.
Estudios de Imagen:
●Tomografía Computarizada (CT): Imágenes detalladas del abdomen.
●Resonancia Magnética (MRI): Imágenes precisas de los órganos internos.
●Tomografía por Emisión de Positrones (PET): Detección de células cancerosas activas.
Estudios de Laboratorio:
●Análisis de sangre para detectar anemia y evaluar la función hepática.
●Pruebas genéticas y moleculares en algunos casos.
Caso Clínico
Datos del Paciente
●Edad: 78 años
●Sexo: Femenino
●País: Puerto Rico
Historia Médica Reciente
La paciente presentó una masa gástrica significativa que requirió intervención quirúrgica de manera urgente. Pérdida de peso significativa y apetito, además paciente presentaba intolerancia de alimentos junto con vómitos al ingerir cualquier tipo de alimento.
Procedimiento Quirúrgico Realizado (9 de mayo de 2024)
●Laparotomía Exploratoria: Se realizó una incisión quirúrgica en el abdomen para explorar y evaluar la extensión de la masa gástrica.
●Gastrectomía Subtotal con Reconstrucción
Roux-en-Y: Se removió una parte significativa del estómago (gastrectomía subtotal) debido a la presencia de un tumor grande.
●Esofagoyeyunostomía: Para restablecer la continuidad del tracto gastrointestinal después de la gastrectomía, se conectó el esófago directamente al yeyuno (parte media del intestino delgado).
●Biopsia de Páncreas e Hígado: Para evaluar e identificar la presencia de cáncer.
Motivo de la Intervención
La paciente presentaba un tumor gástrico de gran tamaño, el cual le impedía alimentarse y esto fue la causa principal para realizar la cirugía. La naturaleza y el tipo exacto del tumor (por ejemplo, si era benigno o maligno) no se detallan, pero el tamaño y la localización del tumor hicieron necesaria una intervención quirúrgica extensa.
Objetivos de la Cirugía
●Remoción del Tumor: El principal objetivo era eliminar la masa tumoral para aliviar los síntomas y prevenir posibles complicaciones.
●Restaurar la Función Gastrointestinal: La esofagoyeyunostomía (Roux-en-Y) se realizó para asegurar que la paciente pudiera seguir teniendo una función digestiva adecuada después de la resección del estómago.
Seguimiento y Recuperación
●Postoperatorio Inmediato: Monitoreo cercano en la unidad de cuidados intensivos (UCI) o en una unidad de recuperación para asegurar la estabilidad del paciente y manejar cualquier complicación postoperatoria.
●Rehabilitación Nutricional: Adaptación a un nuevo régimen dietético debido a la reducción del tamaño del estómago y la nueva conexión esofagoyeyunal.
●Evaluación Oncológica: Si el tumor resultó ser maligno, se requerirá una evaluación adicional
para determinar la necesidad de tratamientos adyuvantes como quimioterapia o radioterapia.
Patología
A) Páncreas, cuerpo, biopsia:
●Glándulas atípicas dentro del estroma fibroso, con marcado efecto de electrocauterio: Se identificaron glándulas que no tienen una apariencia normal dentro del tejido fibroso del páncreas. Además, hay un efecto significativo del electrocauterio, que es el daño causado por el calor utilizado durante la biopsia.
B) Hígado, biopsia:
●Parénquima hepático subcapsular con colangitis ascendente aguda: El tejido del hígado cercano a la superficie presenta inflamación aguda de los conductos biliares (colangitis ascendente), indicando una infección en los conductos biliares que se está extendiendo hacia el hígado.
C) Estómago, gastrectomía parcial:
●Melanoma maligno involucrando tejido gastroesofágico, ver nota: Se encontró melanoma maligno en el tejido donde el estómago se conecta con el esófago.
●Pólipo glandular fúndico: Se identificó un pólipo (crecimiento benigno) en las glándulas de la parte superior del estómago (fondo gástrico).
●Los márgenes son negativos para malignidad: Los bordes del tejido extraído durante la cirugía no contienen células cancerosas, lo que indica que el tumor ha sido removido completamente.
●Siete ganglios linfáticos; no se identifica neoplasia (0 de 7): Se examinaron siete ganglios linfáticos y ninguno de ellos contiene células cancerosas.
Conclusión
En conclusión, se espera que la paciente, luego ser haber sido intervenida
quirúrgicamente para tratar el melanoma maligno gástrico, pase por una evaluación integral con estudios de imagen como PET-CT y MRI para determinar la posible extensión del melanoma y descartar metástasis. El enfoque será decidido por un equipo multidisciplinario, donde se considerarán opciones de tratamiento adicionales como inmunoterapia, terapias dirigidas o quimioterapia, dependiendo del estadio y características del melanoma. La paciente requerirá un seguimiento estrecho para gestionar la adaptación a la nueva dinámica digestiva post-gastrectomía, incluyendo apoyo nutricional y programas de rehabilitación. Además, se realizarán controles periódicos para monitorear la posible recurrencia del melanoma y ajustar el tratamiento según sea necesario, con el objetivo de proporcionar un manejo integral y optimizar la calidad de vida a largo plazo.
Referencias
Mayo Foundation for Medical Education and Research. (n.d.). Gastric cancer overview. Mayo Clinic. https://medprofvideos.mayoclinic.org/ videos/gastric-cancer-overview
Melanoma cancer treatment. moffitt. (n.d.). https://www.moffitt.org/cancers/melanoma/
Metastatic malignant melanoma of the gastrointestinal tract - mayo clinic proceedings. (n.d.). https://www.mayoclinicproceedings.org/ article/S0025-6196(11)61899-5/fulltext
Ravi, A. (2008, November). Primary gastric melanoma: A rare cause of upper gastrointestinal bleeding. Gastroenterology & hepatology. https:// www.ncbi.nlm.nih.gov/pmc/articles/PMC3104388/
Signs and symptoms of advanced melanoma. Macmillan Cancer Support. (n.d.). https://www. macmillan.org.uk/cancer-information-and-support/ melanoma/advanced-melanoma/signs-andsymptoms-of-advanced-melanoma
U.S. National Library of Medicine. (n.d.). Melanoma: Medlineplus Enciclopedia Médica. MedlinePlus. https://medlineplus.gov/spanish/ency/ article/000850.htm
Conoce el trabajo de tus compañeros de universidad...
La ciudad es un poema de José
Ernesto
En el ambiente de Sebastián De Hoyos Rodríguez
Por Natty de Natalia
Viaje Qlinario de José Dávila
Habla Gamer de Carlos Rodríguez Sotomayor
Sánchez Dávila
Anti-racismo
Anti-homofóbia
Anti-machismo
Anti-transfóbia
Anti-xenofóbia
¡Equidad para todes!